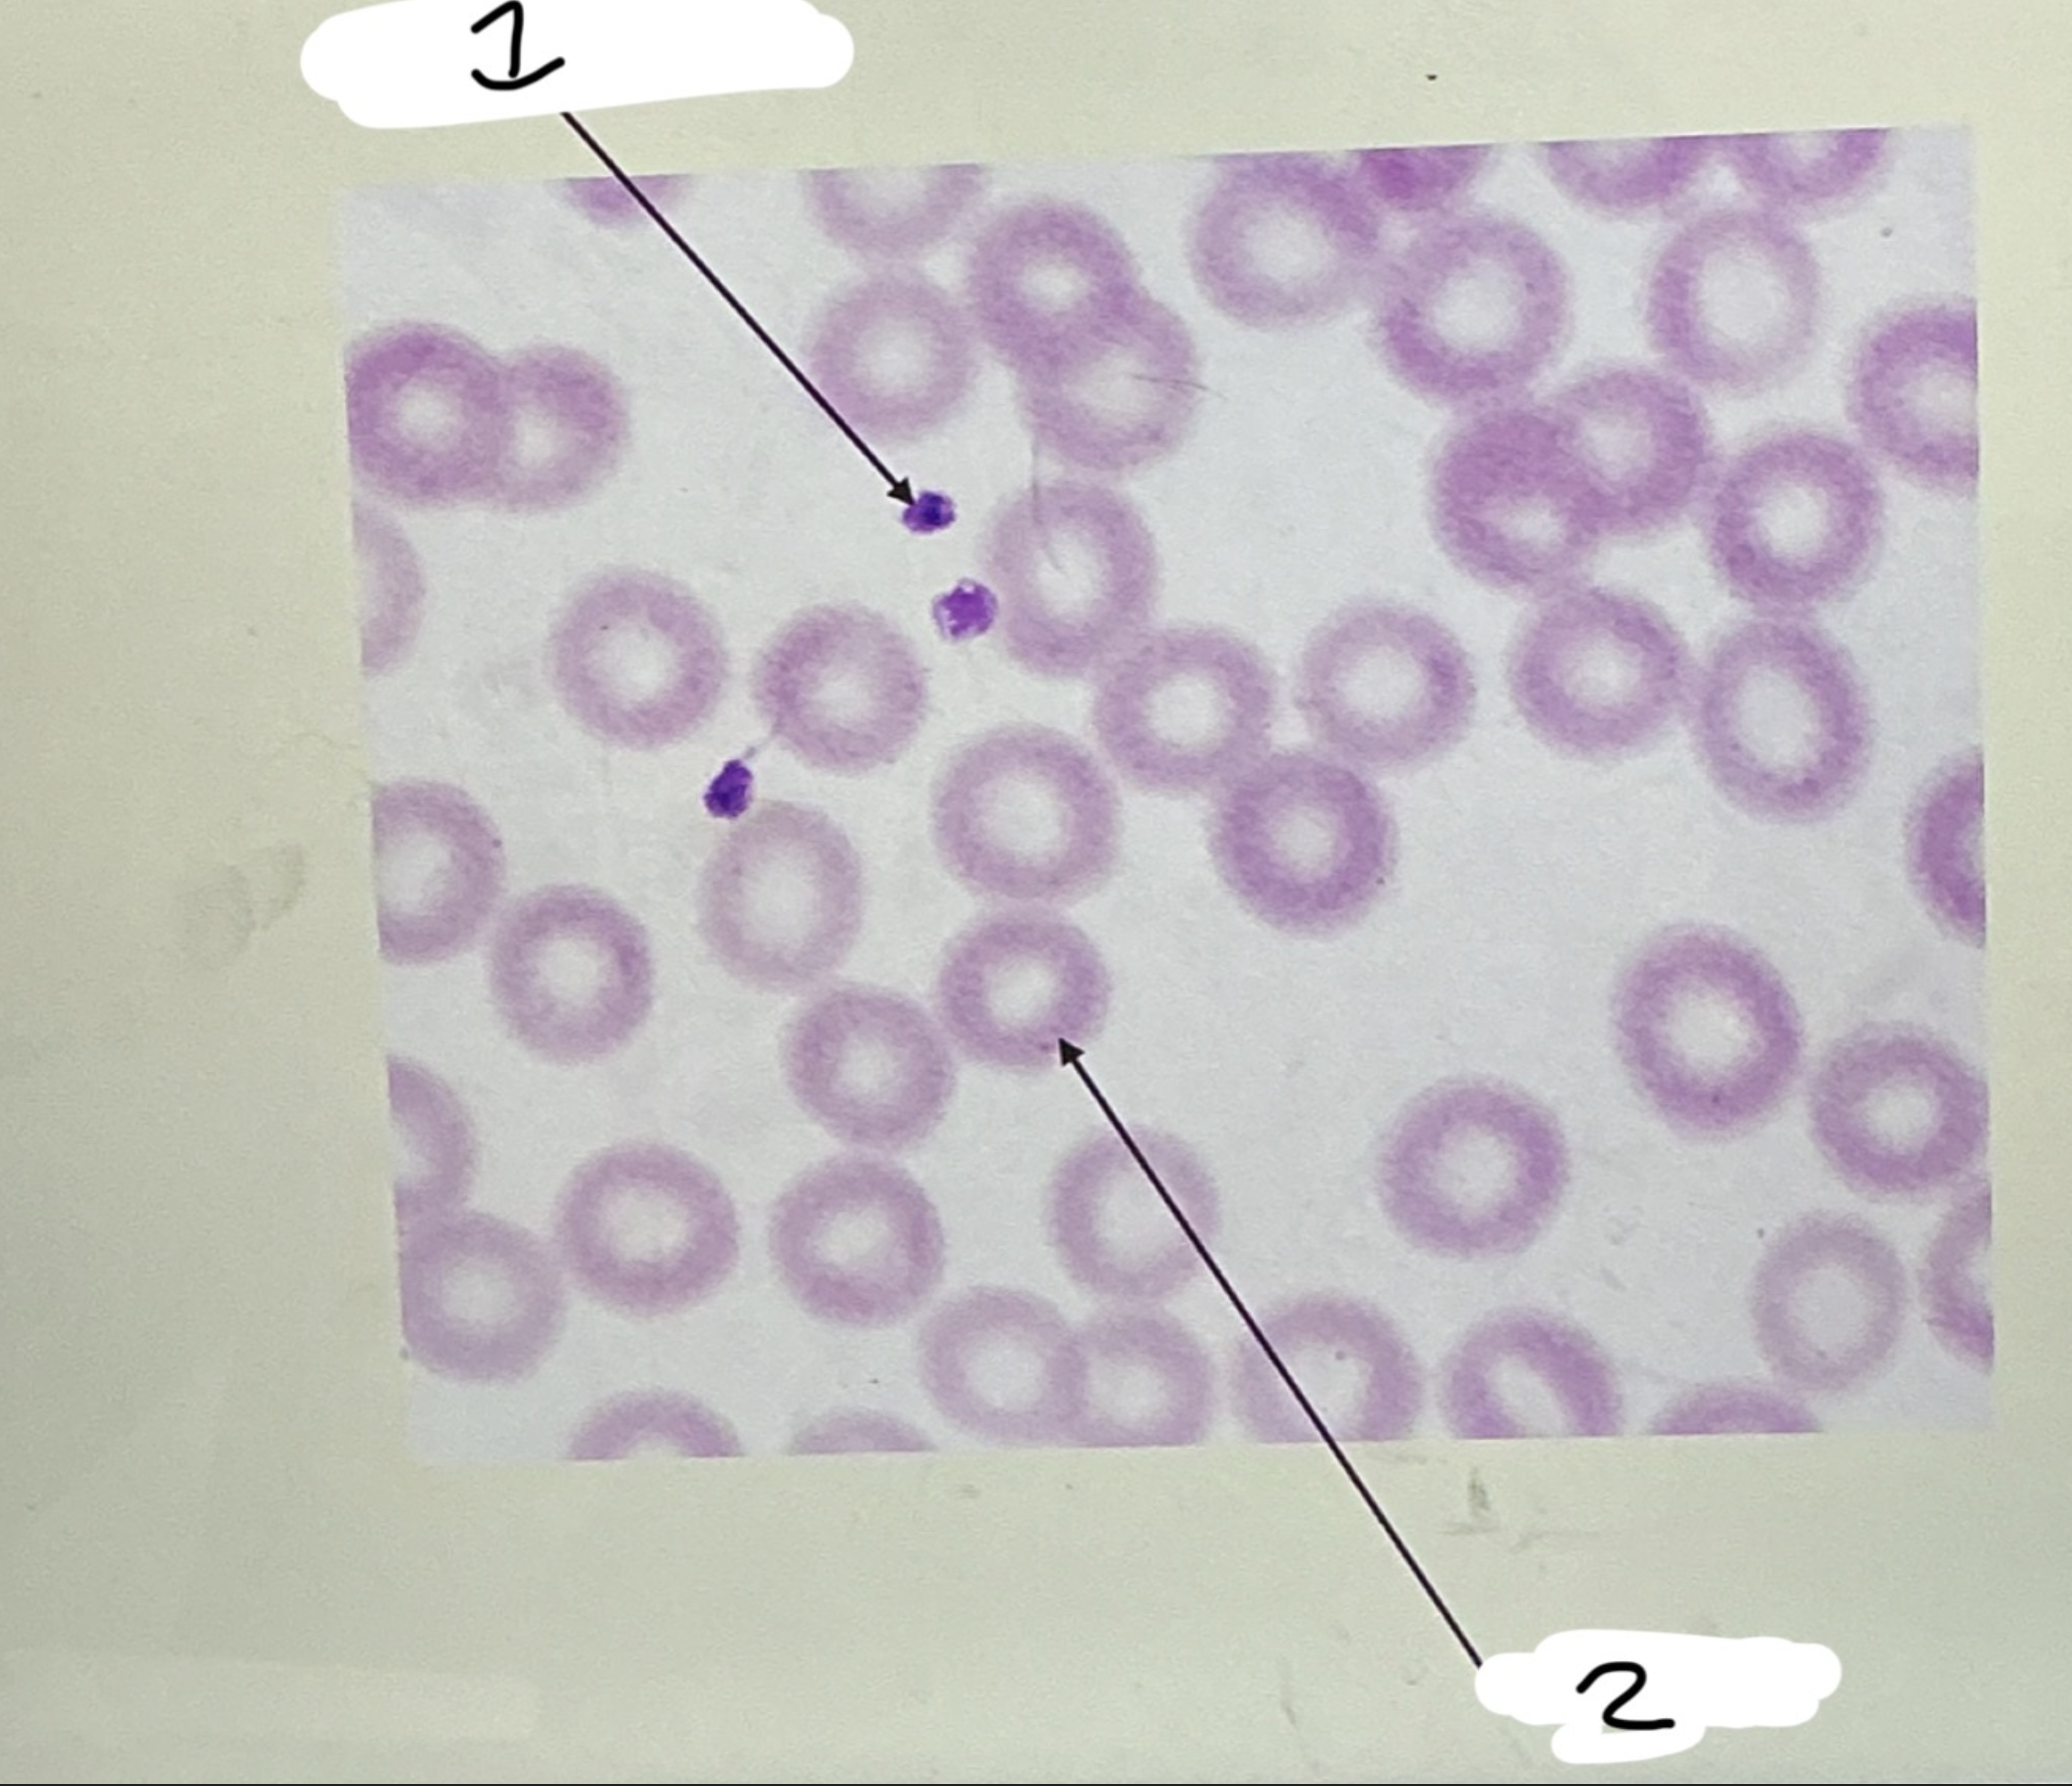
<p>RBCs</p><p>■ Most common XX XX</p><p>■ Do not have a XX</p><p>■ Carry oxygen via XX</p><p>1:XX</p><p>2.XX</p>
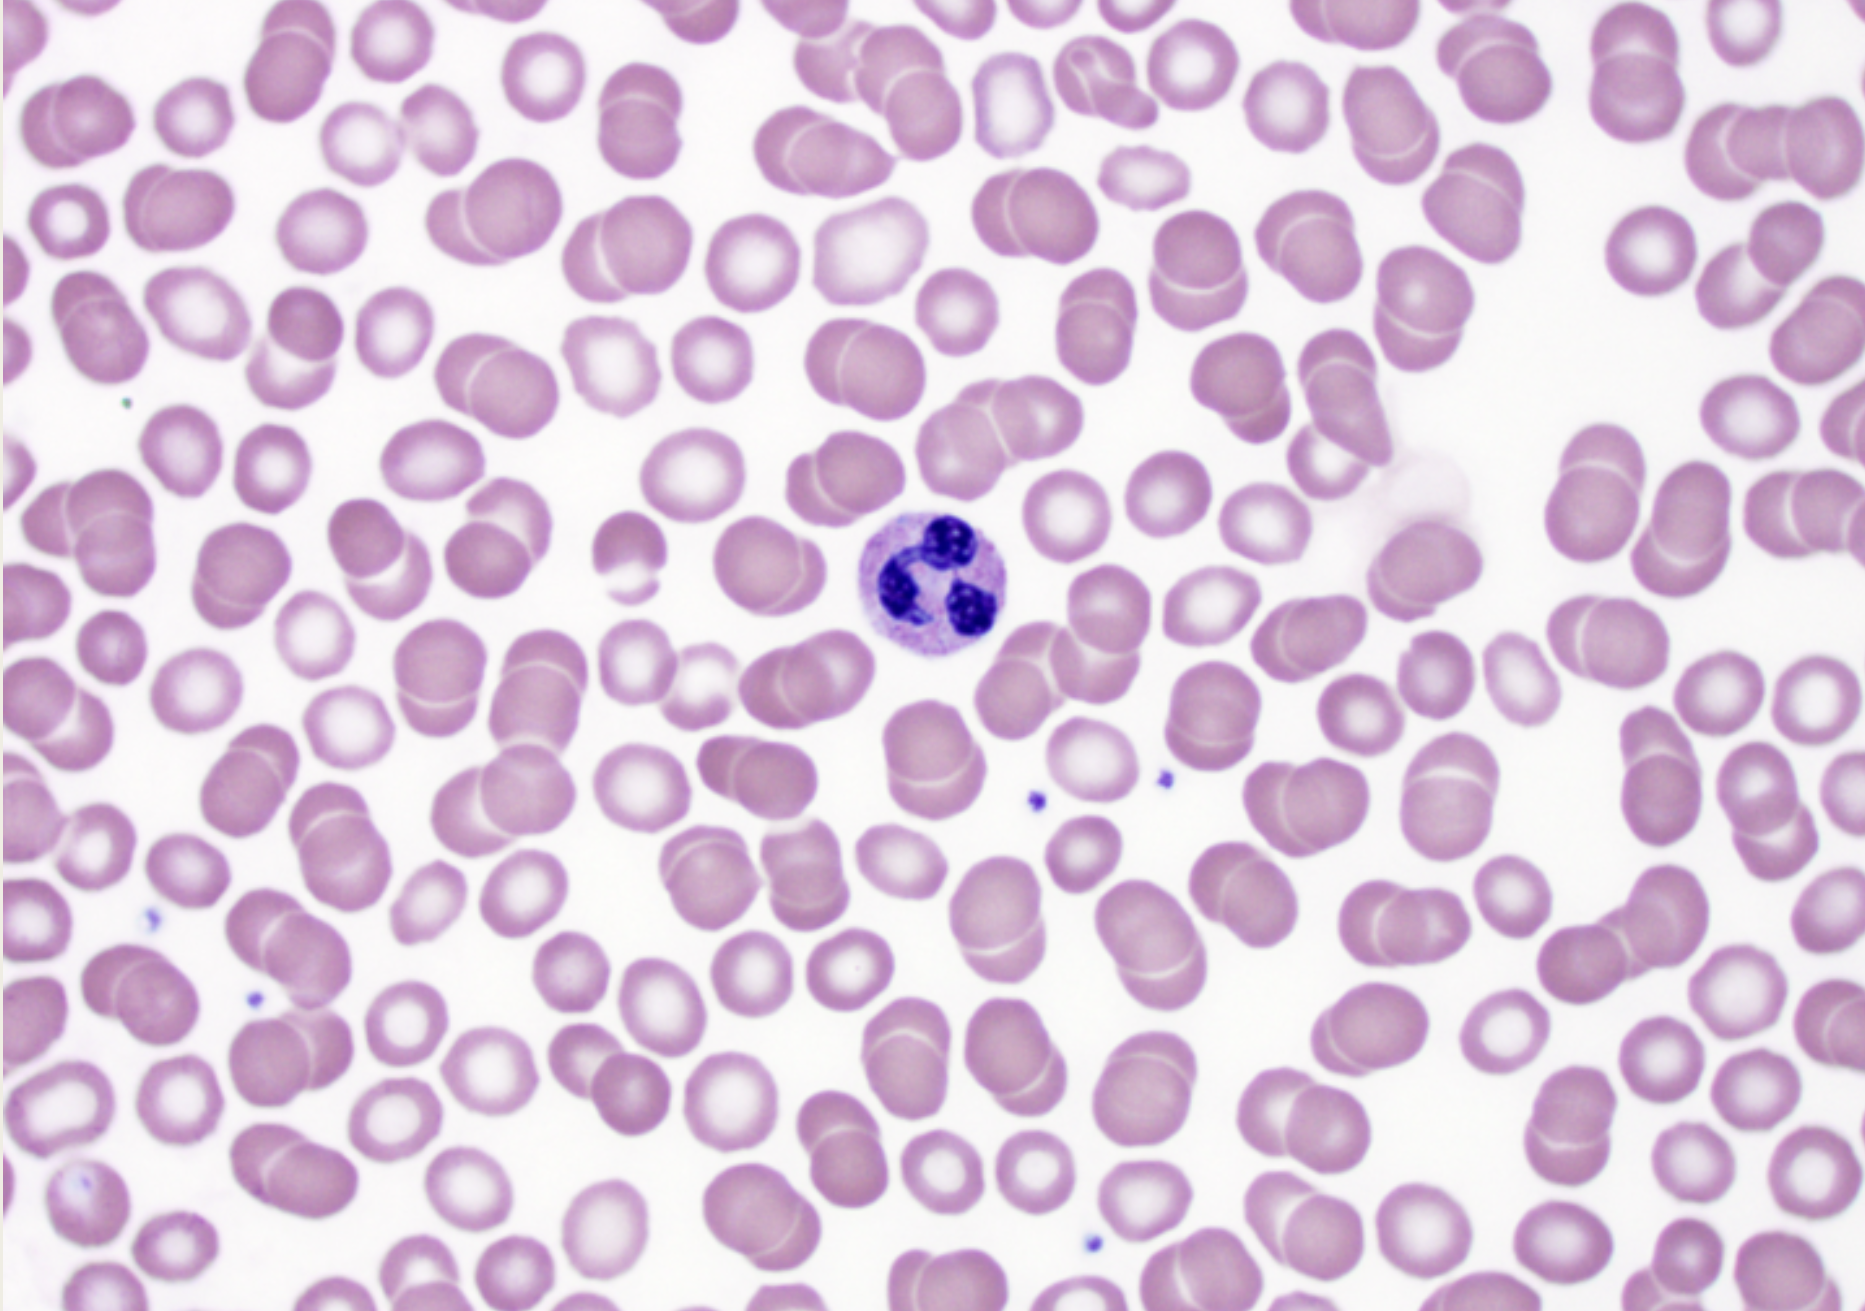
<p>Neutrophils</p><p>■ 3-5-lobed XX</p><p>■ XX</p><p>■ Normally, the first to</p><p>XX at the site of an</p><p>XX</p><p>■ Ingest XX and</p><p>release XX to kill</p><p>XX</p><p></p>
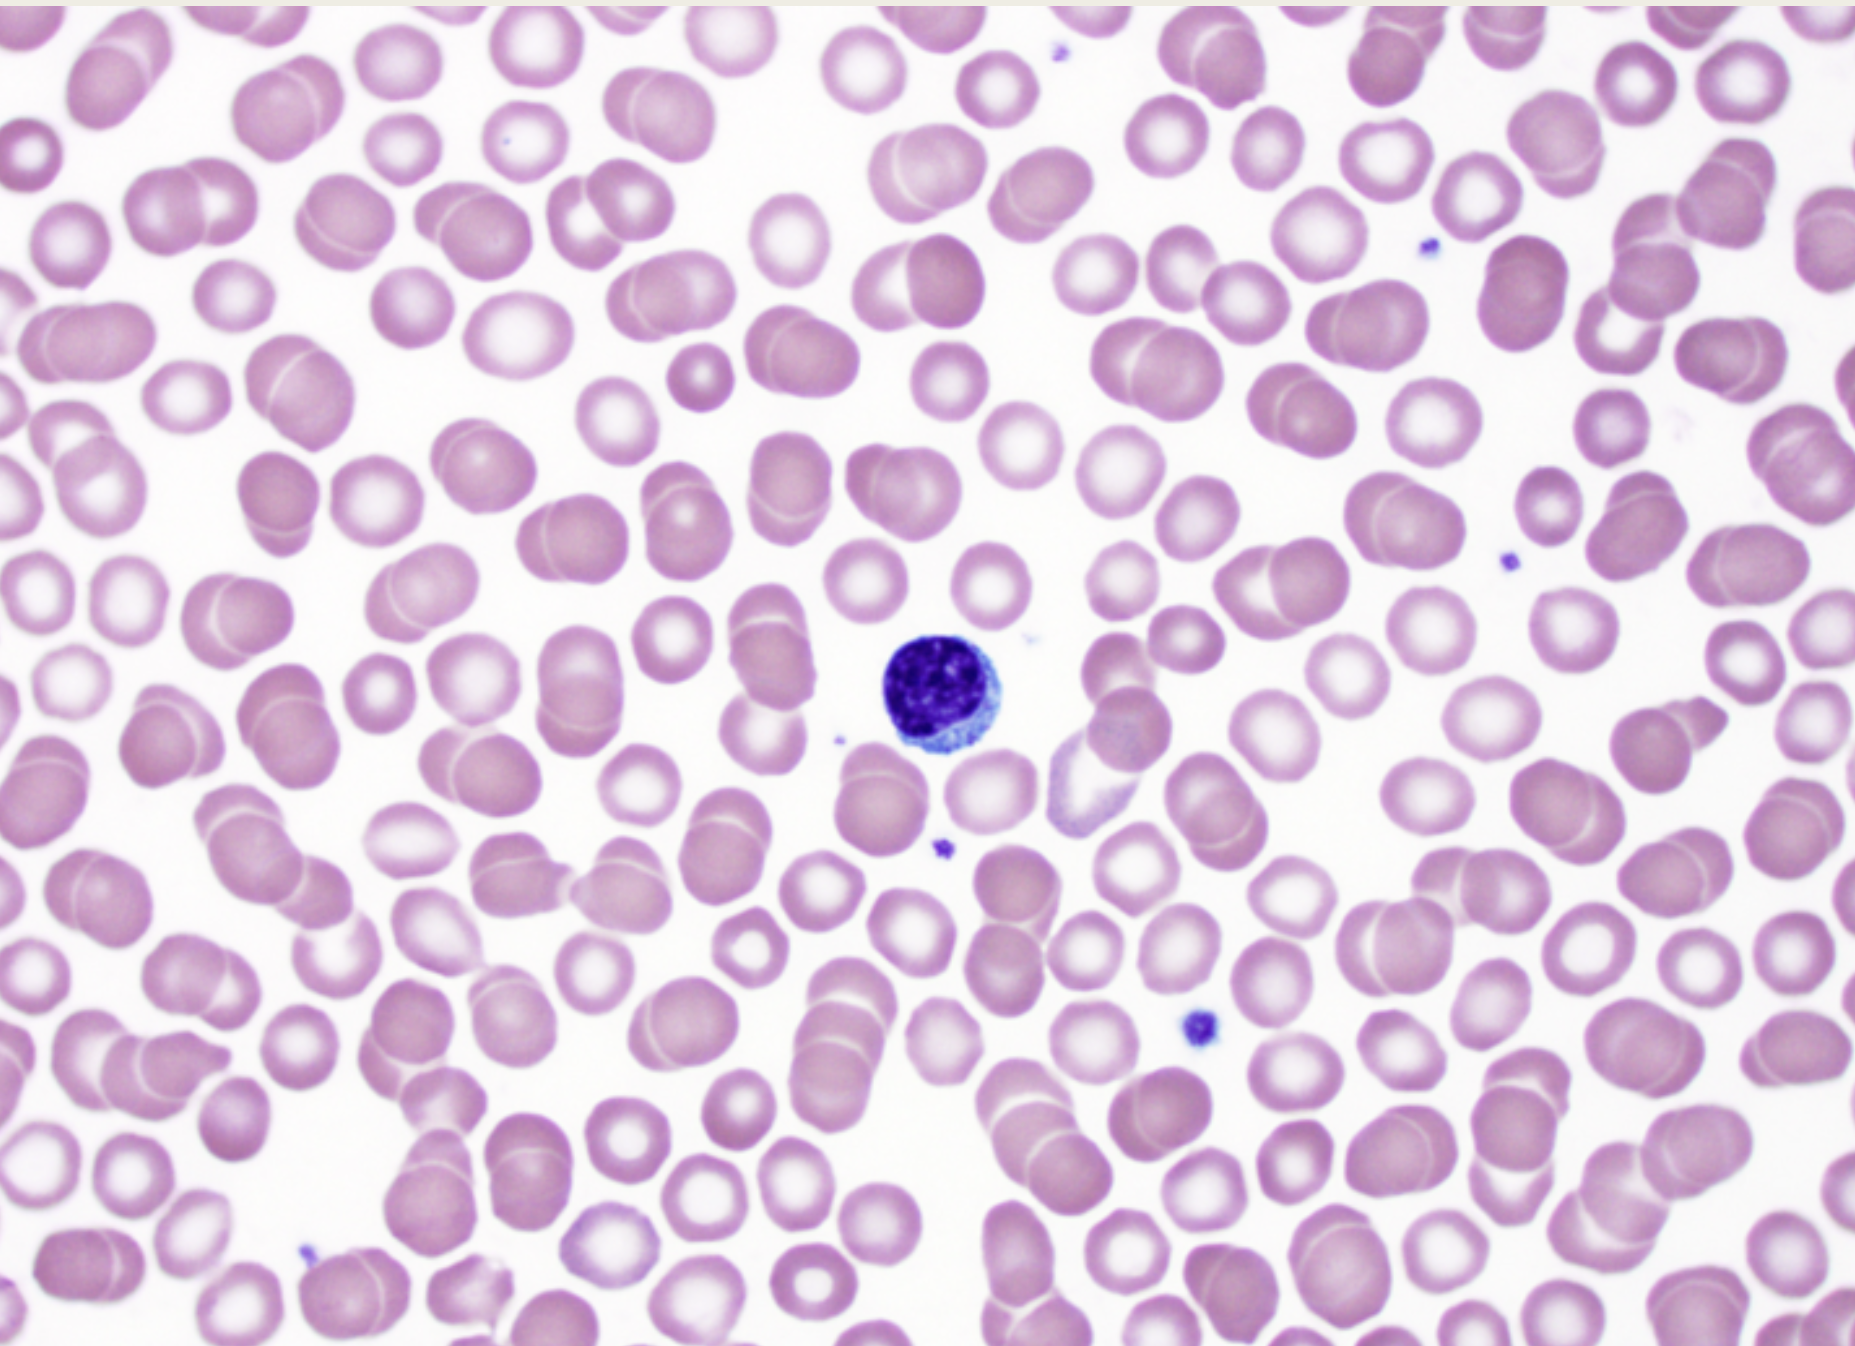
<p>Lymphocytes</p><p>■ One XX,XX</p><p>nucleus</p><p>■ XX</p><p>■ XX WBC</p><p>■ XX Types (X cells &amp; X</p><p>Cells)</p><p></p>
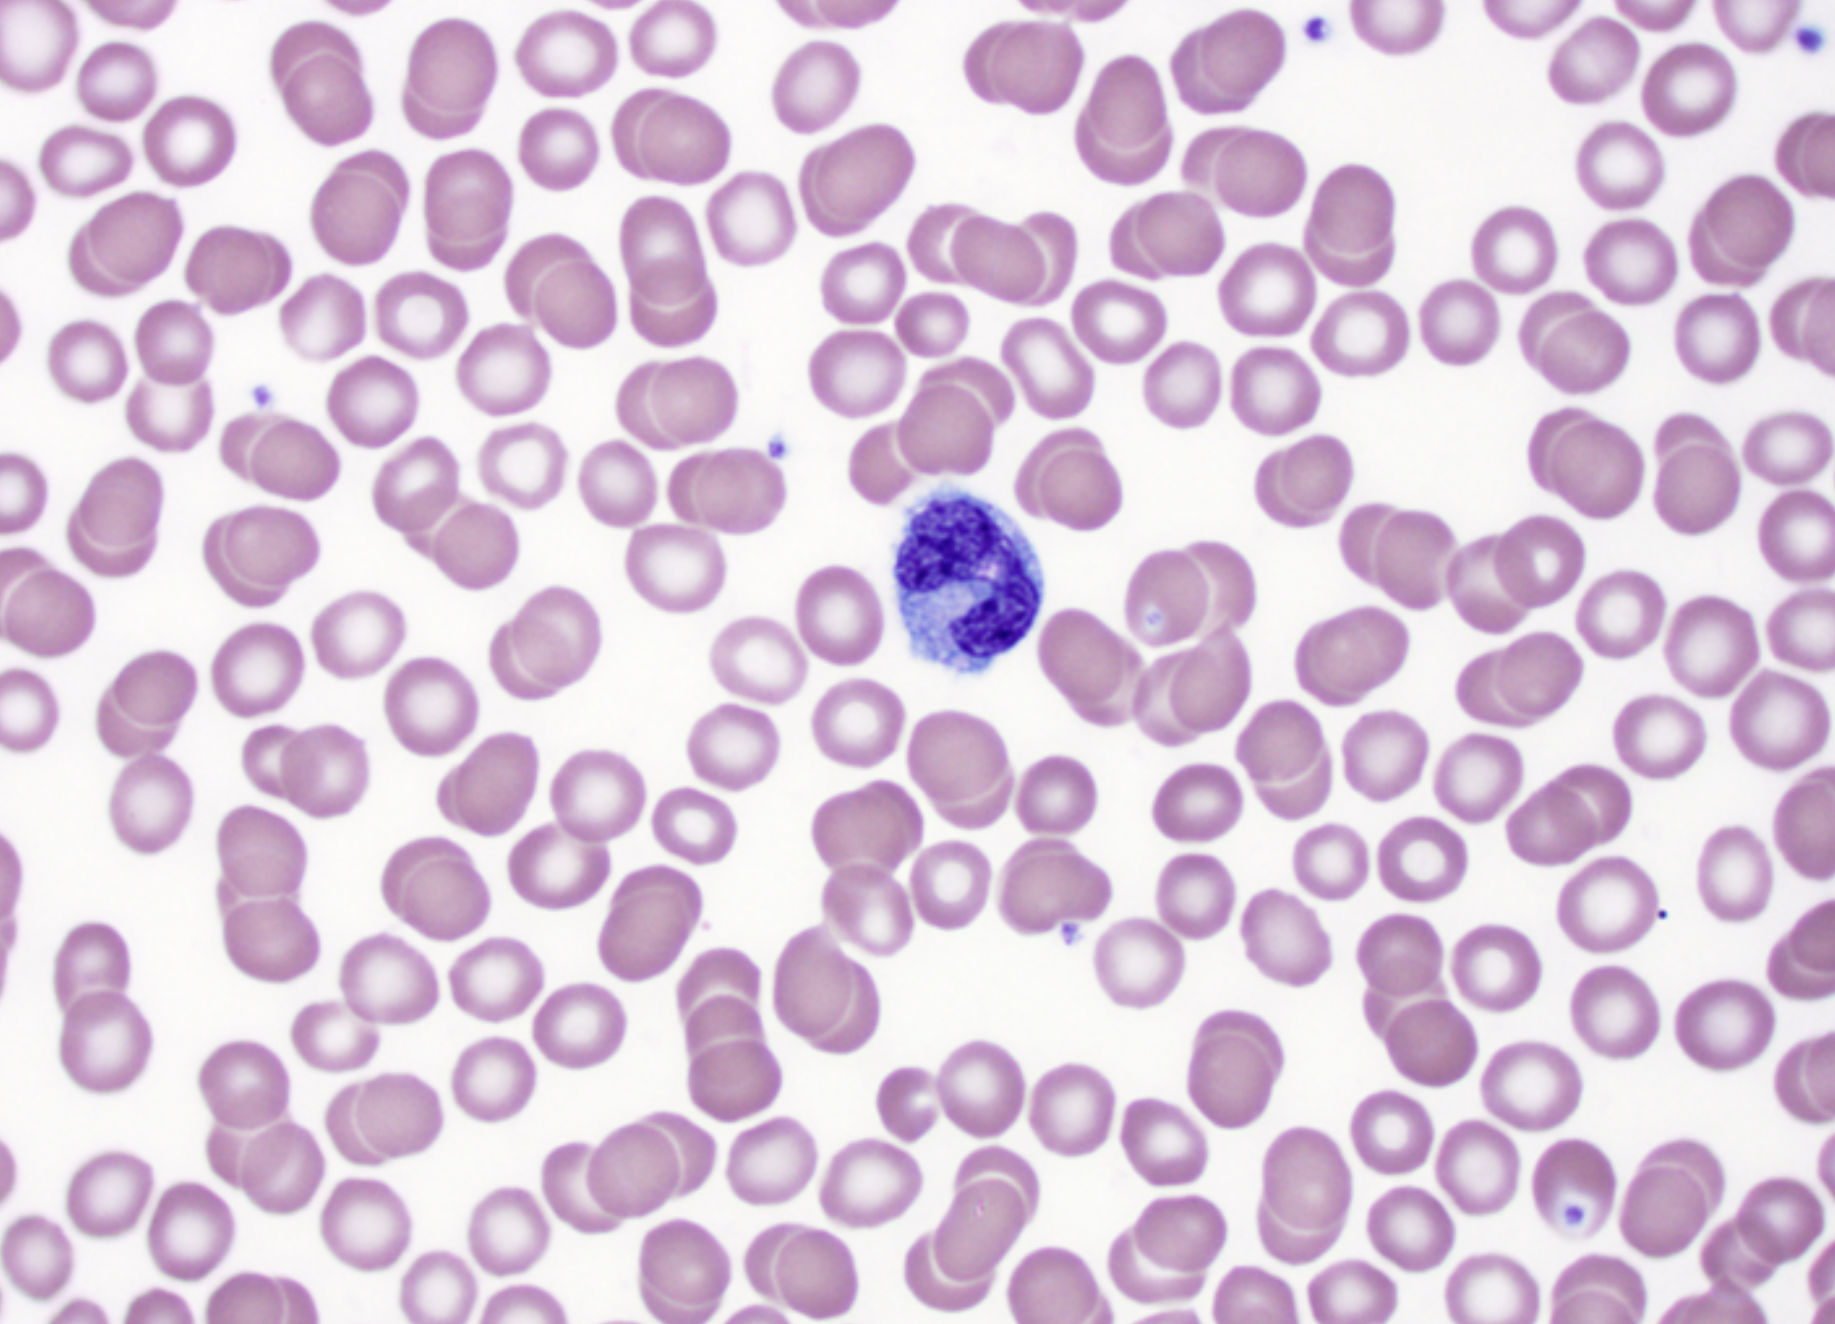
<p>Monocytes</p><p>■ XX-XX nucleus</p><p>■ XX</p><p>■ Largest XX</p><p>■ Turn into XX</p><p>■ XX presentation</p><p></p>
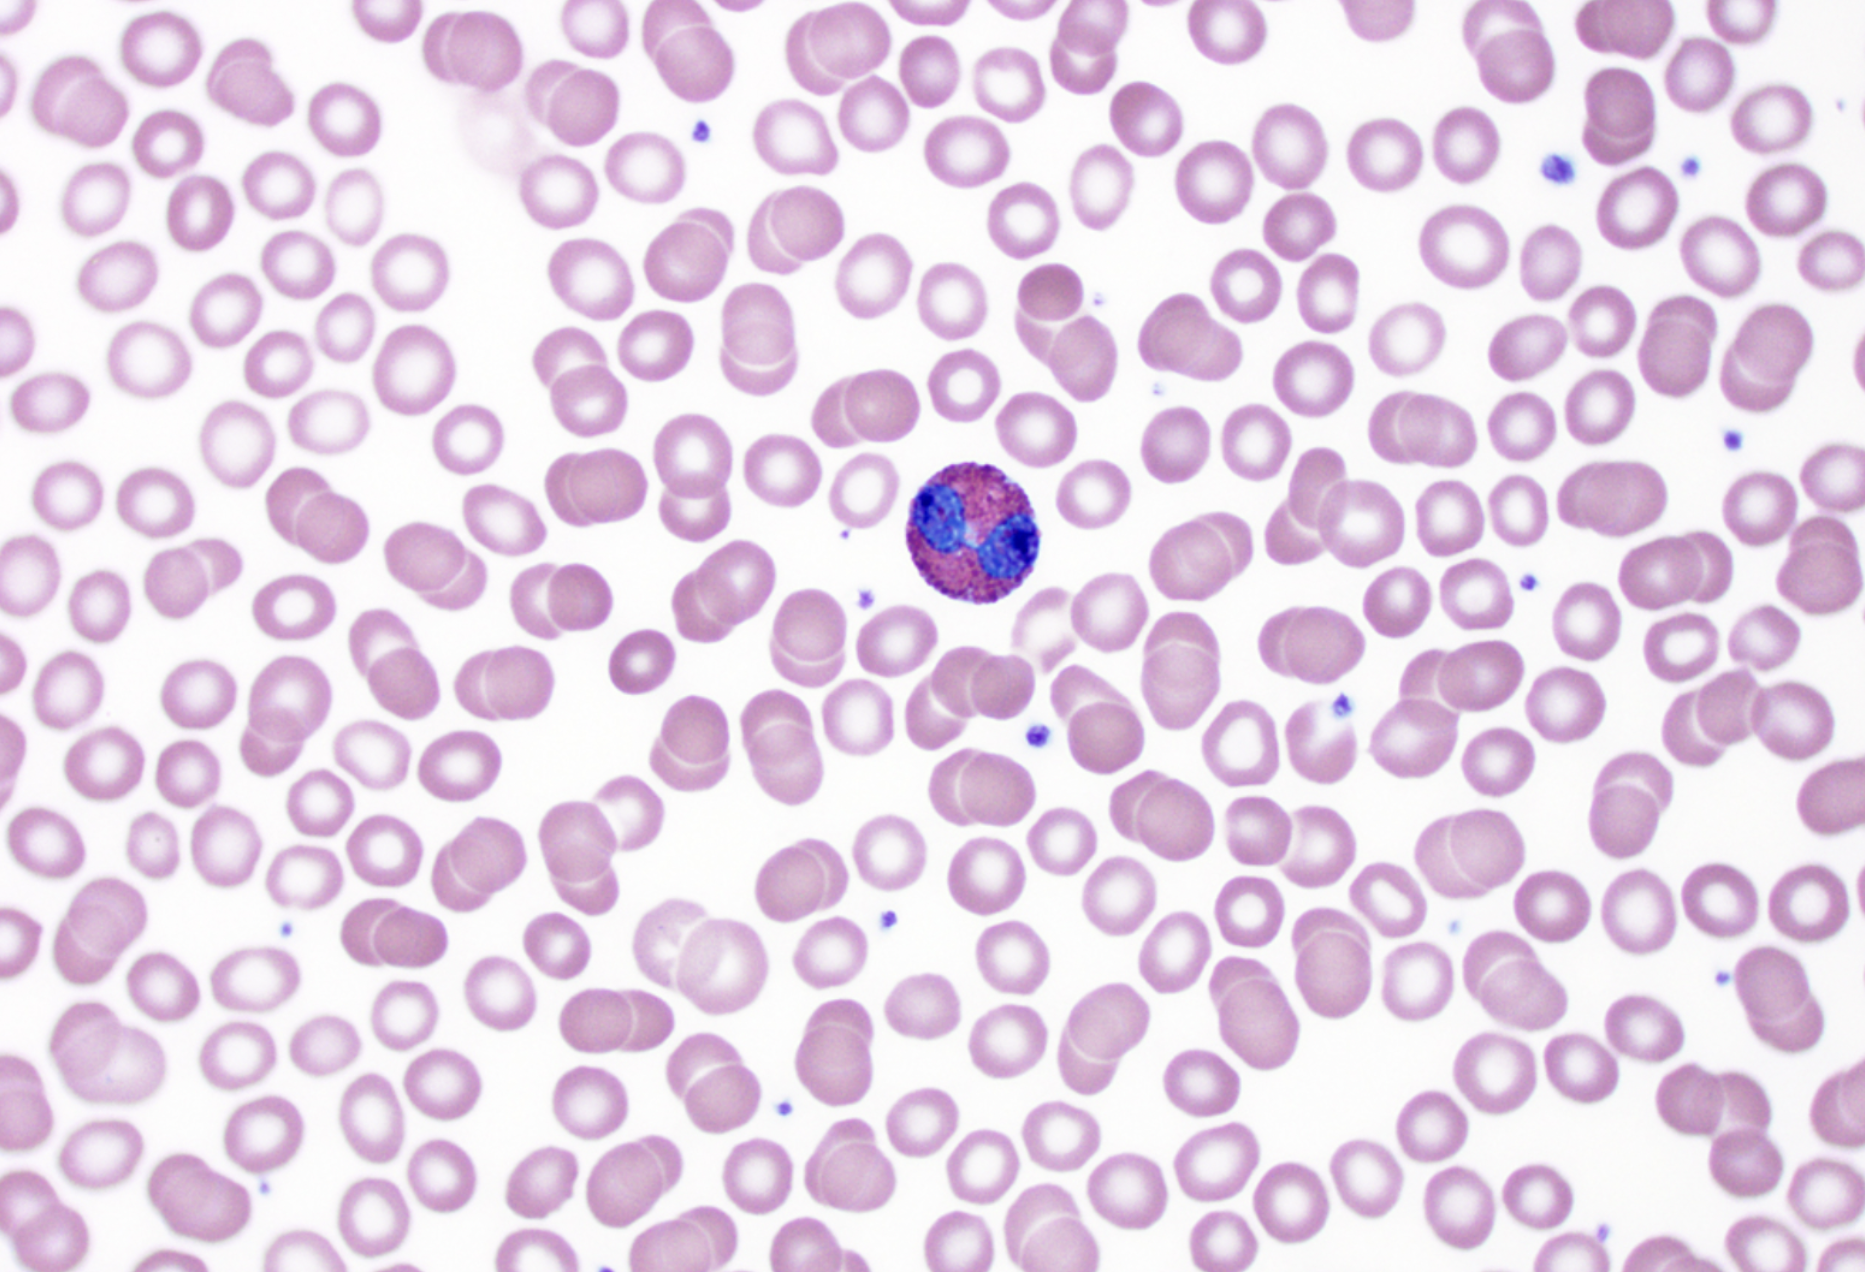
<p>Eosinophils</p><p>■ X-XX nucleus</p><p>■ XX</p><p>■ Fight XX</p><p>infections &amp; involved</p><p>with XX XX</p><p></p>
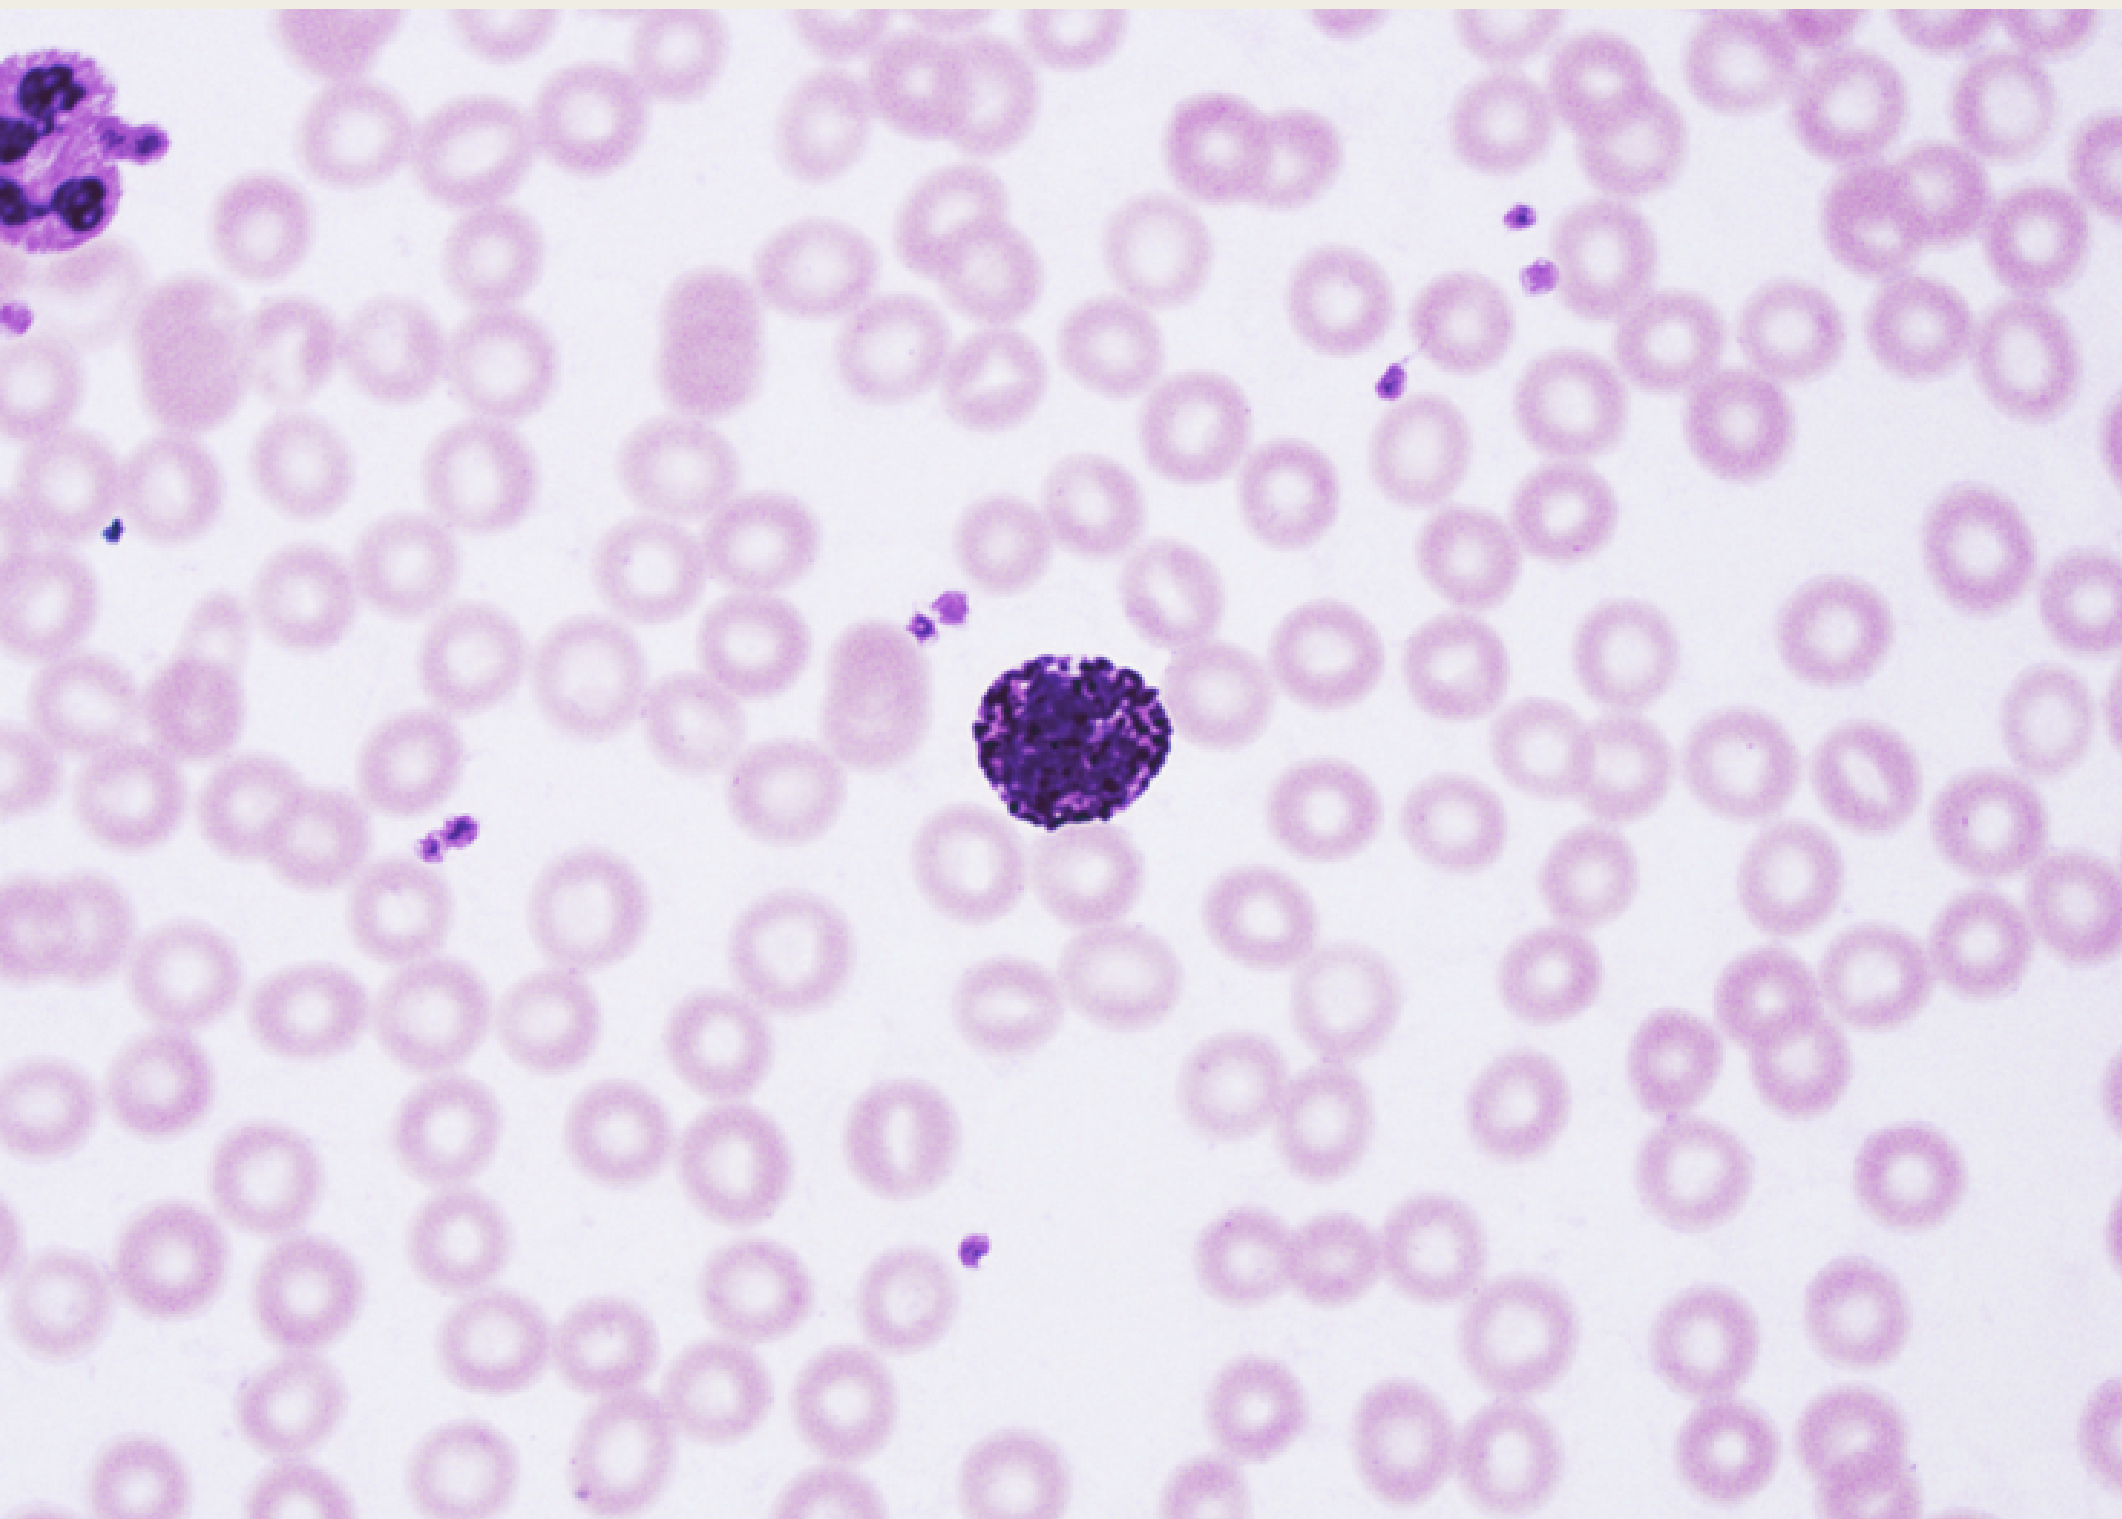
<p>Basophils</p><p>■ XX-shaped XX</p><p>(difficult to see due to</p><p>dark staining)</p><p>■ XX</p><p>■ Involved in XX</p><p>■ Prevents XX from</p><p>clotting too quickly</p><p></p>
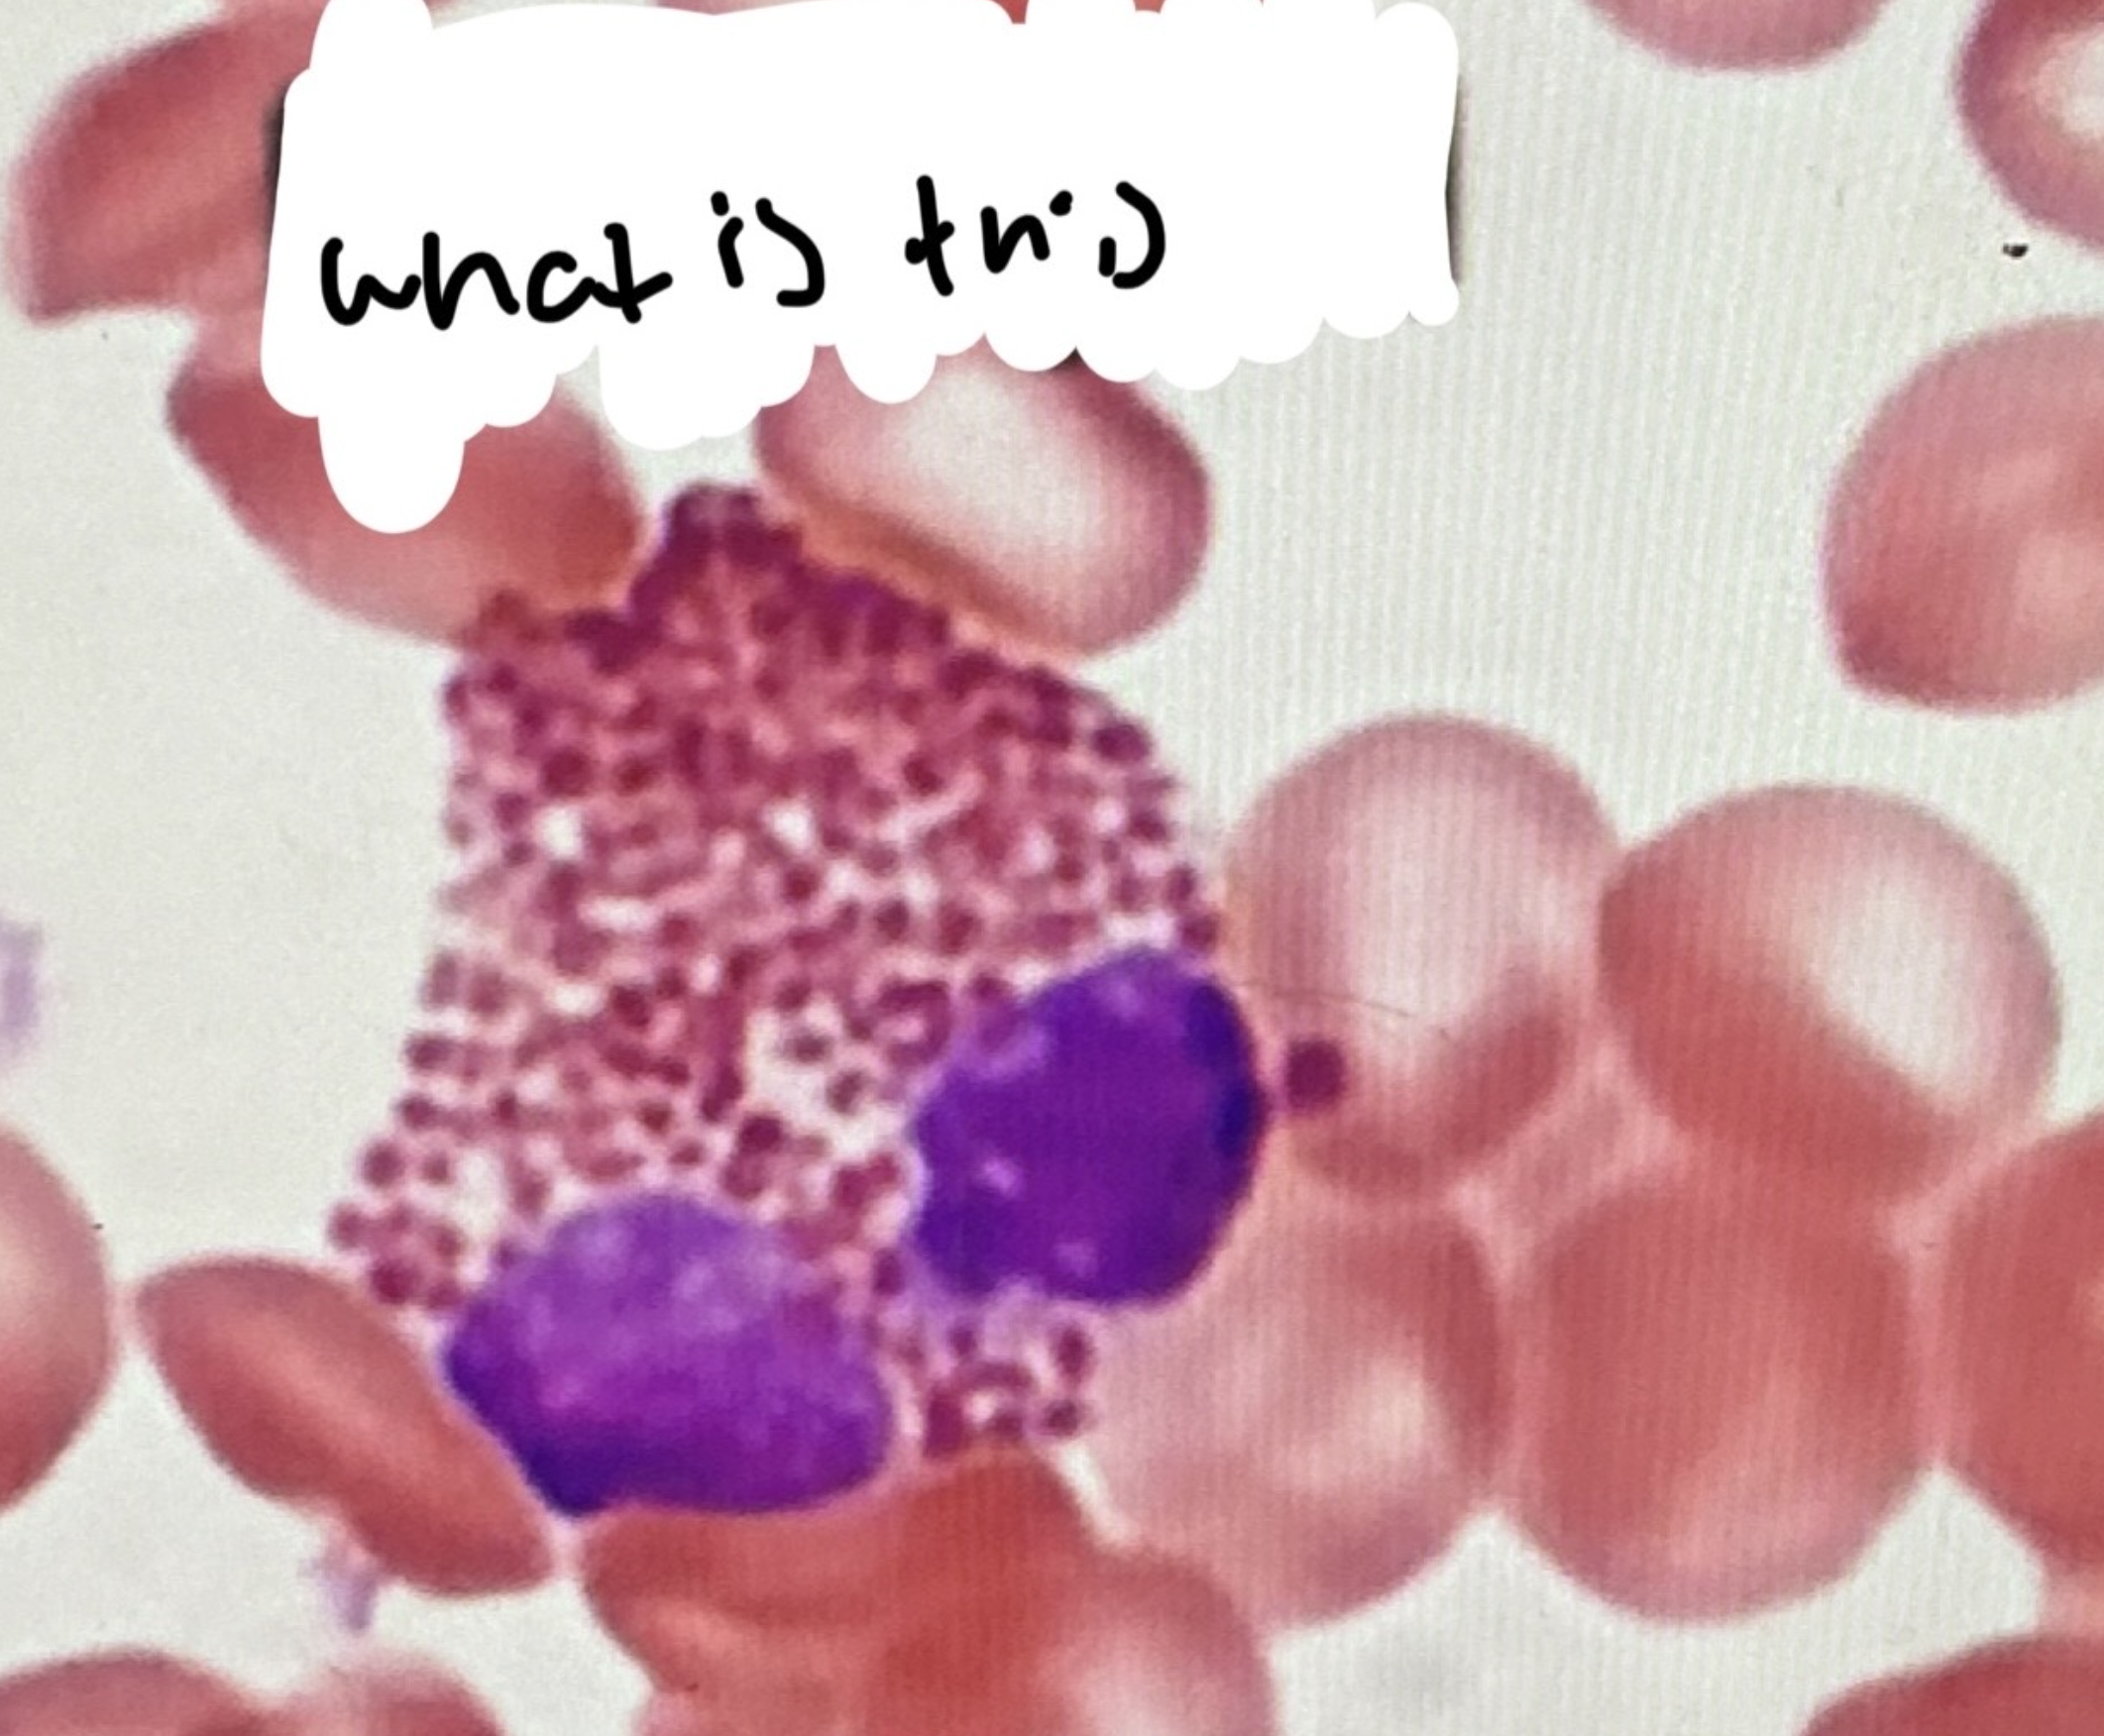
<p>WHATS THIS</p>
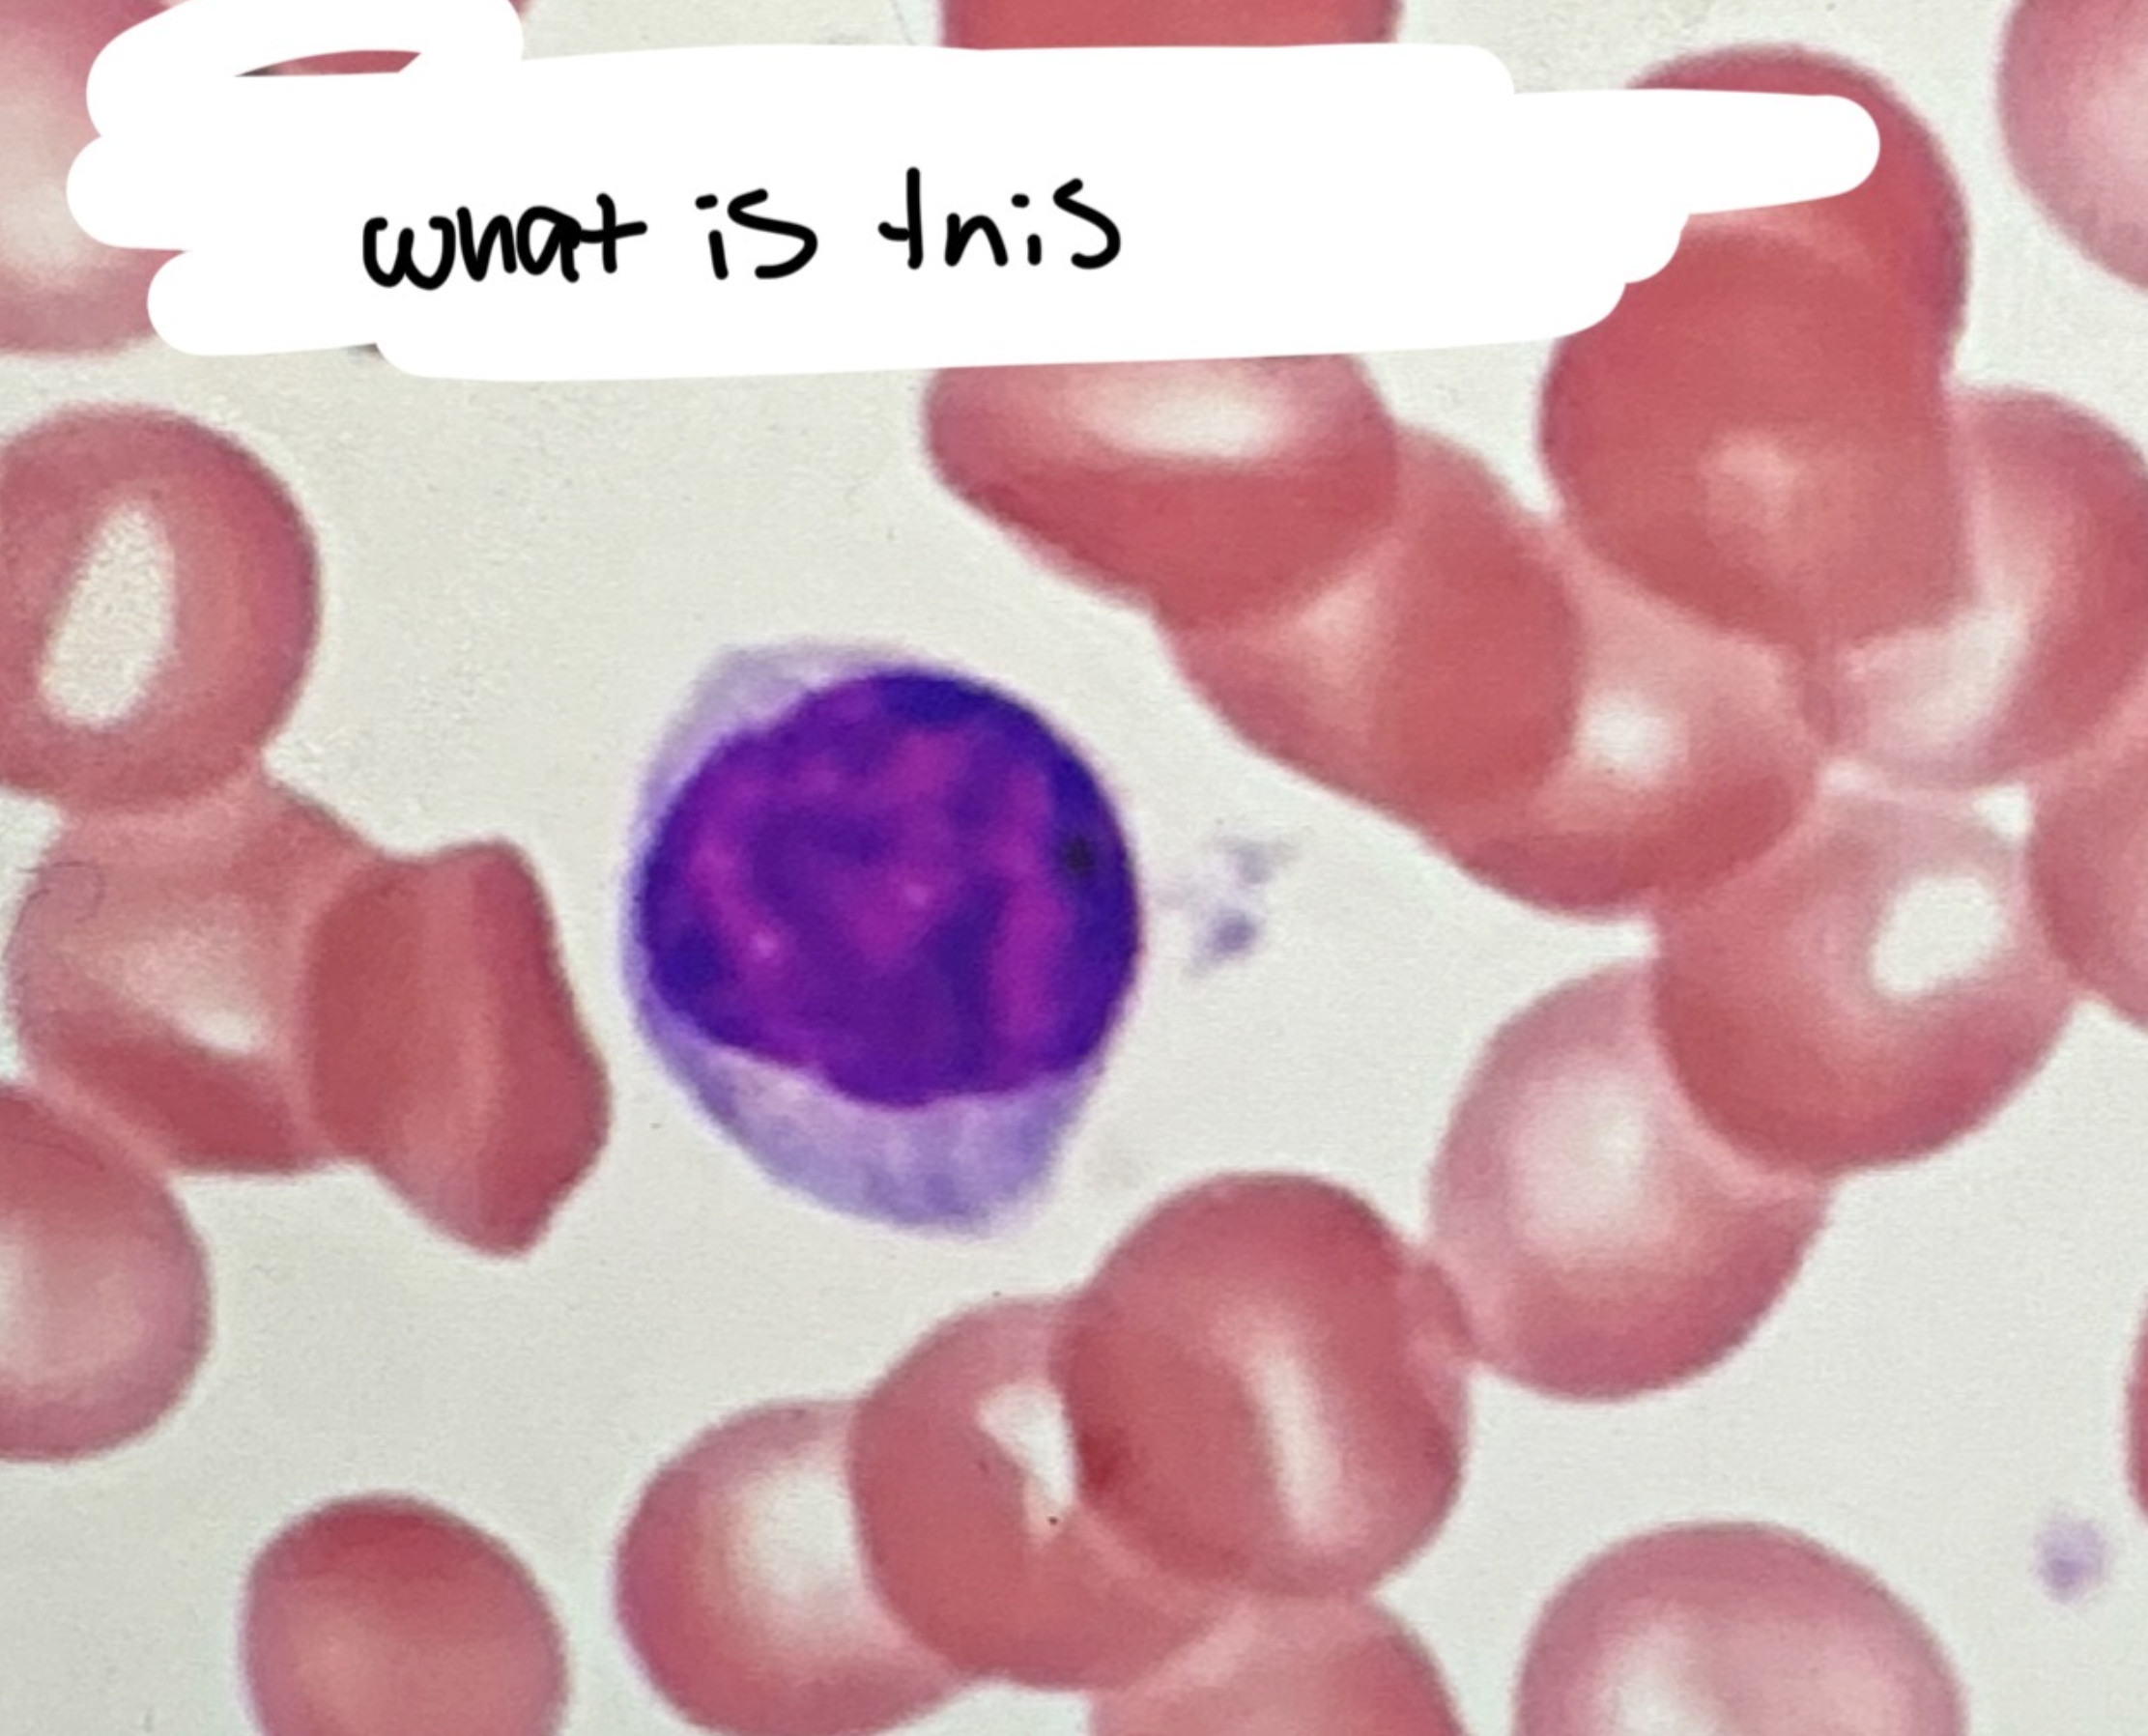
<p>WHATS THIS</p>

lab exam 3
1/49
There's no tags or description
Looks like no tags are added yet.
Name | Mastery | Learn | Test | Matching | Spaced | Call with Kai |
|---|
No analytics yet
Send a link to your students to track their progress
50 Terms
Blood
■ XX XX
■ Formed Elements ~ 45% of total blood volume
– XX XX XX (XXs/XX)
– XX XX Cells (XX/XX)
– XX
■ Plasma ~ 50% of total blood volume
– Contains XX, XX, XX XX, XX, and XX XX
Blood
■ Connective Tissue
■ Formed Elements ~ 45% of total blood volume
– Red Blood Cells (RBCs/erythrocytes)
– White Blood Cells (WBCs/leukocytes)
– Platelets
■ Plasma ~ 50% of total blood volume
– Contains water, lipids, dissolved substances, proteins, and clotting factors
RBCs
■ Most common XX XX
■ Do not have a XX
■ Carry oxygen via XX
1:XX
2.XX
RBCs
■ Most common blood cells
■ Do not have a nucleus
■ Carry oxygen via Hemoglobin
1.PLATELETS
2.RBCS
WBCs
■ Types of white blood cells (listed from most common to least common)
– XX
– XX
– XX
– XX
– XX
■ Never Let Monsters Eat Babies!
WBCs
■ Types of white blood cells (listed from most common to least common)
– Neutrophils
– Lymphocytes
– Monocytes
– Eosinophils
– Basophils
■ Never Let Monsters Eat Babies!
Neutrophils
■ 3-5-lobed XX
■ XX
■ Normally, the first to
XX at the site of an
XX
■ Ingest XX and
release XX to kill
XX
Neutrophils
■ 3-5-lobed nucleus
■ Granular
■ Normally, the first to
arrive at the site of an
infection
■ Ingest pathogens and
release enzymes to kill
microorganisms
Lymphocytes
■ One XX,XX
nucleus
■ XX
■ XX WBC
■ XX Types (X cells & X
Cells)
Lymphocytes
■ One large, unlobed
nucleus
■ Agranular
■ Smallest WBC
■ Two Types (T cells & B
Cells)
Monocytes
■ XX-XX nucleus
■ XX
■ Largest XX
■ Turn into XX
■ XX presentation
Monocytes
■ Horseshoe-shaped
nucleus
■ Agranular
■ Largest WBC
■ Turn into macrophages
■ Antigen presentation
Eosinophils
■ X-XX nucleus
■ XX
■ Fight XX
infections & involved
with XX XX
Eosinophils
■ 2-lobed nucleus
■ Granular
■ Fight parasitic
infections & involved
with allergic reactions
Basophils
■ XX-shaped XX
(difficult to see due to
dark staining)
■ XX
■ Involved in XX
■ Prevents XX from
clotting too quickly
Basophils
■ S-shaped nucleus
(difficult to see due to
dark staining)
■ Granular
■ Involved in allergic
reactions
■ Prevents blood from
clotting too quickly

WHATS THIS
a neutrophil
WHATS THIS
EOSINOPHIL
WHATS THIS
LYMPHOCYTES

WHAT IS THIS
MONOCYTES
EXCERSICE 21: THE HEART
Layers of
the Heart
■ XX: Inner
layer
■ XX: Middle
muscular layer
■ XX: Outer heart
wall
■ XX XX: Outer
connective tissue that
surrounds the heart
Layers of
the Heart
■ Endocardium: Inner
layer
■ Myocardium: Middle
muscular layer
■ Epicardium: Outer heart
wall
■ Pericardial Sac: Outer
connective tissue that
surrounds the heart

1.XX
2.XX
3.XX
4.XX
5.XX
6.XX
7.XX
1.FIBROUS PERICARDIUM
HEART WALL:
2.EPICARDIUM
3. MYOCARDIUM
4. ENDOCARDIUM
5. FIBROUS PERICARDIUM
SERIOUS PERICARDIUM
6.PARIETAL LAYER
7.VISCERAL LAYER

Heart
Chambers
■ Right Atrium (RA)
■ Right Ventricle (RV)
■ Left Atrium (LA)
■ Left Ventricle (LV)
Heart
Chambers
■ Right Atrium (RA)
■ Right Ventricle (RV)
■ Left Atrium (LA)
■ Left Ventricle (LV)

1.XX
2.XX
3.XX
4.XX
5.XX
6.XX
7.XX
8.XX
9.XX
10.XX
11.XX
12.XX
13.XX
14.XX
15.XX
16.XX
1.SUPERIOR VENA CAVA
2.PULMONARY ARTERY
3.PULMONARY VEINS
4.PULMONARY VALVE
5.TRICUSPID VALVE
6.INFERIOR VENA CAVA
7.PAPILLARY MUSCLES
8.Aorta
9.PULMONARY ARTERY
10.PULMONARY VEINS
11.AORTIC VALVE
12.BICUSPID VALVE
13.CHORDAE TENTINEA
14.PAPILLARY MUSCLES
15.APEX
16. INTERVENTICULAR SEPTUM
Heart Structures: Functions
■ Valves (Mitral, Tricuspid, Pulmonary, Aortic):XX XX of XX
■ Pulmonary Arteries: Carry XX blood from the XX to the XX
■ Pulmonary Veins: Carry XX blood from the XX to the XX
■ Aorta: Distributes XX blood to the XX of the XX
■ Venae Cavae: Carry XX from the rest of the XX back to theXX
■ Chordae Tendineae: Anchor the XX to the XX XX of the XX XX
■ Interventricular Septum: XX the XX
Heart Structures: Functions
■ Valves (Mitral, Tricuspid, Pulmonary, Aortic): Prevent backflow of blood
■ Pulmonary Arteries: Carry DEOXYGENATED blood from the heart to the lungs
■ Pulmonary Veins: Carry OXYGENATED blood from the lungs to the heart
■ Aorta: Distributes oxygenated blood to the rest of the body
■ Venae Cavae: Carry blood from the rest of the body back to the heart
■ Chordae Tendineae: Anchor the valves to the papillary muscles of the heart
walls
■ Interventricular Septum: Separates the ventricles

1.XX
2.XX
3.XX
4.XX
5.XX
6.XX
7,XX
8.XX
9.XX
10.XX
11.XX
12.XX
13.XX
1.SUPERIOR VENA CAVA
2.PULMONARY VALVE
3.RIGHT ATRIUM
4.TRICUSPID VALVE
5.RIGHT VENTRICLE
6.AORTA
7.PULMONARY ARTERY
8.LEFT ATRIUM
9.BICUSBID VALVE
10.CHOROID TENDINAE
11.PAPILLARY MUSCLES
12.LEFT VENTRICLE
13.INTERVENTICULAR SEPTUM

1.XX
2.XX
3.XX
4.XX
5.XX
6.XX
7.XX
8.XX
9.XX
10.XX
11.XX
1.LEFT ATRIUM
2.BICUSBID VALVE
3.CHOROID TENDINAE
4.LEFT VENTRICLE
5.APEX
6.AORTIC VALVE
7.RIGHT ATRIUM
8.TRICUSPID VALVE
9.CHOROID TENDINAE
10.RIGHT VENTRICLE
11.INTERVENTICULAR SEPTUM
Blood Vessels
Arteries
■ Tend XX from the XX
■ XX/XX Lumen
■ XX XX XX
■ Typically contain XX blood (pulmonary arteries are the
exception)
■ Tend away from the heart
■ Circular/round Lumen
■ Thicker tunica media
■ Typically contain oxygenated
blood (pulmonary arteries are the
exception)
Veins
■ XX towards the XX
■ Contain XX
■ Typically have an XX XX
noncircular lumen
■ Typically contain XX
blood (pulmonary veins are the
exception)
Veins
■ Tend towards the heart
■ Contain valves
■ Typically have an oddly-shaped,
noncircular lumen
■ Typically contain deoxygenated
blood (pulmonary veins are the
exception)

1.XX
2.XX
1.LUMEN OF ARTERY
2. LUMEN OF VEIN
Tunica Externa
– XX XX
– Has a XX XX XX
■ Tunica Media
– XX XX
– Composed of XX XX
– May also contain XX XX in XX XX
■ Tunica Interna
– XX XX
– Consists of XX XX and XX XX XX
Tunica Externa
– Outer layer
– Has a connective tissue sheath
■ Tunica Media
– Middle layer
– Composed of smooth muscle
– May also contain elastic tissue in thicker arteries
■ Tunica Interna
– Inner layer
– Consists of connective tissue and simple squamous epithelium

Xxx

1.XX
2.XX
3.XX
4.XX
5.XX
6.XX
7.XX
8.XX
1.VALVE
2.VEIN
3.ARTERY
4.TUNICA INTERNA
5.INTERNAL ELASTIC MEMBRANE
6.TUNICA MEDIA
7.EXTERNAL ELASTIC MEMBRANE
8.TUNICA EXTERNA
Systemic Arteries
Aorta, carotid, subclavian, brachiocephalic,
mesenteric, iliac arteries
Systemic Arteries
Aorta, carotid, subclavian, brachiocephalic,
mesenteric, iliac arteries
Systemic Veins
Saphenous veins, jugular, median cubital,
cephalic and basilic
Systemic Veins
Saphenous veins, jugular, median cubital,
cephalic and basilic
Veins of the
Head and
Neck
■ Internal, External, and
Anterior Jugular Veins
Veins of the
Head and
Neck
■ Internal, External, and
Anterior Jugular Veins

1.XX
2.XX
3.XX
1.BRACHIOCEPHALIC ARTERY
2.LEFT COMMON CAROTID ARTERY
3.LEFT SUBCLAVIAN ARTERY

1.XX
2.XX
3.XX
4.XX
1.FACIAL ARTERY
2.COMMON CAROTID ARTERY
3.SUPERFICIAL TEMPORAL ARTERY
4.JUGULAR VEIN

1.XX
2.XX
3.XX
4.XX
5.XX
6.XX
7.XX
1.SUPERIOR MESENTERIC
2.COMMON ILIAC
3.EXTERNAL ILIAC
4.CELIAC TRUNK
5.RENAL
6.INFERIOR MESENTERIC
7.INTERNAL ILIAC

1.XX
2.XX
3.XX
4.XX
5.XX
6.XX
7.XX
8.XX
9.XX
10.XX
11.XX
12.XX
13.XX
1.SUBCLAVIAN
2.AXILLARY
3.BRACHIAL
4.RADIAL
5.ULNAR
6.PALMAR ARCH
7.DORALIS PEDIS
8.PLANTAR ARCH
9.DEEP FEMORAL
10.FEMORAL
11.POPLITEAL
12.ANTERIOR TIBIAL
13.POSTERIOR TIBIAL

1.XX
2.XX
3.XX
1.LEFT COMMON CAROTID
2.BRACHIOCEPHALIC TRUNK
3.LEFT SUBCLAVIAN
Functions of the lymphatic system
■ XX XX
– Production, maintenance, and distribution of lymphocytes
■ Maintain XX XX
■ Transportation of XX, XX, an XX XX
Functions of the lymphatic system
■ Immune response
– Production, maintenance, and distribution of lymphocytes
■ Maintain blood volume
■ Transportation of hormones, nutrients, and waste products
Components of the Lymphatic
System
■ XX
– Interstitial fluid that flows through the lymphatic vessels to transport WBCs
and waste products
■ XX XX
– Collecting Vessels: return lymph to the venous system
– Lymph capillaries: return lymph to the collecting vessels
■ XX XX
– Primary & Secondary
Components of the Lymphatic
System
■ Lymph
– Interstitial fluid that flows through the lymphatic vessels to transport WBCs
and waste products
■ Lymphatic Vessels
– Collecting Vessels: return lymph to the venous system
– Lymph capillaries: return lymph to the collecting vessels
■ Lymphoid Tissues
– Primary & Secondary
Lymphoid Tissues
■ Primary (Site of lymphocyte development)
–XX XX
– XX
■ Secondary (Site of Lymphocytes residence and
response)
– XX
– XX XX
– XX
– XX
– XX XX
Lymphoid Tissues
■ Primary (Site of lymphocyte development)
– Bone Marrow
– Thymus
■ Secondary (Site of Lymphocytes residence and
response)
– Spleen
– Lymph Nodes
– Appendix
– Tonsils
– Peyer’s Patches

what is this
lymph nodes

what structure is this:
1.xx
2.xx
3.xx
4.xx
a lymph node
1.cortex
2.nodules
3.medulla
4.capsule

Respiratory
Epithelium
■ Pseudostratified
Ciliated Columnar
– Lines most of the
XX XX
– Movement of
XX and XX
or microorganisms
Respiratory
Epithelium
■ Pseudostratified
Ciliated Columnar
– Lines most of the
respiratory tract
– Movement of
mucus and debris
or microorganisms

Components of the Upper Respiratory
System
■ XX XX
■ XX XX
■ XX
■ XX XX
■ XX
Components of the Upper Respiratory
System
■ Paranasal Sinuses
■ Nasal Conchae
■ Nose
■ Nasal Cavity
■ Pharynx

Sinuses
■ Production of XX
1.XX
2.XX
Production of mucus
1.FRONTAL SINUS
2.SPHENOIDAL SINUS

XX
■ Warms and humidifies
the air breathed in
through the nose
1.XX
2.XX
3.XX
NASAL CONCHAE
1.SUPERIOR
2.MIDDLE
3.INFERIOR

PHARYNX
1.XX
2.XX
3.XX
4.XX
5.XX
1.Nasopharynx
– Superior to the soft
palate
2.Soft
Palate
3. Oropharynx
– Between the soft
palate and base of
the tongue
4.Laryngopharynx
– Inferior to the base
of the tongue
5.EPIGLOTTIS

Components of the Lower Respiratory
SYSTEM:
1.XX
2.XX
3.XX
4.XX
5.XX
1.LARYNX
2.TRACHEA
3.BRONCHII
4.LUNGS
5.BRONCHIOLES

1.XX
2.XX
3.XX
4.XX
5.XX
6.XX
1.HYOID BONE
2.THYROID CARTILAGE
3.Cricoid Cartilage
4. Tracheal Cartilage
5.LARYNX
6.TRACHEA

1.XX
2.XX
3.XX
4.XX
5.XX
1.Carina of the
Trachea
2.Main Bronchi
3.Lobar/Secondary Bronchi
4.Lobar/Secondary Bronchi
5.Segmental/Tertiary Bronchi

1.XX
2.XX
3.XX
4.XX
5.XX
6.XX
7.XX
8.XX
9.XX
10.XX
11.XX
1.RIGHT LUNG
2. LEFT LUNG
3.SUPERIOR LOBE
4.HORIZONTAL FISSURE
5.MIDDLE LOBE
6.OBLIQUE FISSURE
7.INFERIOR LOBE
8. SUPERIOR LOBE
9.OBLIQUE FISSURE
10.INFERIOR LOBE
11. CARDIAC NOTCH

XX HISTOLOGY
2.XX
3.XX
4.XX
5.XX
LUNG HISTOLOGY
BRONCHIOLE
PULMONARY ARTERY
PULMONARY VEIN
ALVEOLI

what is this?
lungs